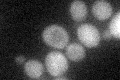
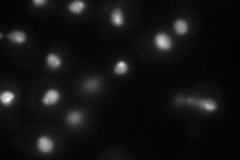
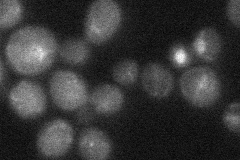

View description
Transcriptional activator involved in regulation of invertase and glucoamylase expression, invasive growth and pseudohyphal differentiation, iron uptake, chromium accumulation, and response to osmotic stress; localizes to the nucleus
Localization:
Intensity:
Fold change:
Significance:
-
C’ GFP library in SD
below threshold16.75 -
N' NOP1pr-GFP in SD
punctate,nucleus75.5949 -
N' TEF2pr-mCherry in SD

nucleus75.7121 -
N' NATIVEpr-GFP in SD
punctate,nucleus24.0962 -
N' TEF2pr-VC and Cyto-VN in SD

#N/A0 -
C’ GFP library in SD+DTT

cytosol14.90.88No -
C’ GFP library in SD+H2O2

cytosol17.121.02No -
C’ GFP library in Starvation Media

cytosol25.581.52No -
C’ GFP library on the background of Pup2-DaMP

below threshold -
C’ GFP library on the background of CCT mutant

below threshold16.36140.976627No
